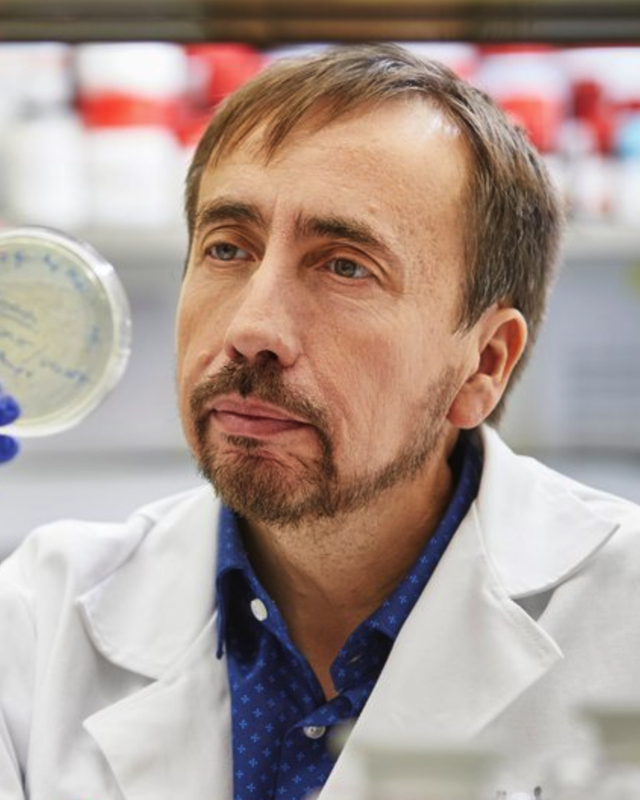
Claudio Soto

Dr. Claudio Soto is the Huffington’s Distinguished University Chair, Professor of Neurology and Director of George and Cynthia Mitchell Center for Alzheimer’s Disease and Related Brain Disorders at The University of Texas Medical School in Houston. Currently he is also the Founder, Vice-President and Chief Scientific Officer of AMPRION Inc.
He received his PhD in biochemistry and molecular biology from the University of Chile in 1993 and was a postdoctoral fellow at the Catholic University of Chile and the New York University School of Medicine, where he became an Assistant Professor in 1995. Between 1999 and 2003, Dr. Soto was Senior Scientist, Chairman of the Department of Molecular Neurobiology and Senior Executive Scientific Advisor for Neurobiology at Serono International in Geneva, Switzerland. Between 2003 and 2008, he served as Director of the George and Cynthia Mitchell Center for Neurodegenerative Diseases and Professor on the Departments of Neurology, Neuroscience & Cell Biology and Biochemistry & Molecular Biology at the University of Texas Medical Branch in Galveston.
Dr. Soto has received numerous awards and has been invited speaker in more than 150 International scientific meetings worldwide. Dr. Soto serves as the Co-Lead of the Biomarker Core for the HADRC, where he directs the detection of alpha-synuclein aggregates in clinical samples. He also remains deeply committed to the future of the field, serving as a dedicated mentor to the next generation of researchers through the REC Core.